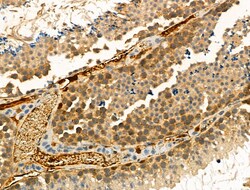
Invitrogen Phospho-FOXO3A (Ser413) Polyclonal Antibody 100 &mu;L; Unconjugated:Antibodies

missing translation for 'onlineSavingsMsg'
Learn More
Learn More
Invitrogen™ Phospho-FOXO3A (Ser413) Polyclonal Antibody


Rabbit Polyclonal Antibody
Marca: Invitrogen™ PA5104594
Questo articolo non è restituibile.
Consulta la politica di reso
Descrizione
Antibody detects endogenous levels of FOXO3A only when phosphorylated at Ser413.
USP48 is a protein containing domains that associate it with the peptidase family C19, also known as family 2 of ubiquitin carboxyl-terminal hydrolases. Family members function as deubiquitinating enzymes, recognizing and hydrolyzing the peptide bond at the C-terminal glycine of ubiquitin. Enzymes in peptidase family C19 are involved in the processing of poly-ubiquitin precursors as well as that of ubiquitinated proteins.
Specifica
| Phospho-FOXO3A (Ser413) | |
| Polyclonal | |
| Unconjugated | |
| FOXO3 | |
| 1110048B16Rik; 2010203A17Rik; AF6q21; AF6q21 protein; C76856; Fkhr2; FKHRL1; FKHRL1P2; forkhead box O3; forkhead box O3a; forkhead box O3A transcription factor; forkhead box protein O3; forkhead homolog (rhabdomyosarcoma) like 1; forkhead in rhabdomyosarcoma-like 1; forkhead protein FKHR2; forkhead, Drosophila, homolog of, in rhabdomyosarcoma-like 1; FOXO2; FOXO3; FOXO-3; FOXO3A | |
| Rabbit | |
| Sequential Chromatography | |
| RUO | |
| 2309, 294515, 56484 | |
| -20°C | |
| Liquid |
| Immunohistochemistry (Paraffin), Western Blot | |
| 1 mg/mL | |
| PBS with 50% glycerol and 0.02% sodium azide; pH 7.4 | |
| O43524, Q9WVH4 | |
| FOXO3 | |
| A synthesized peptide derived from human FOXO3(Accession O43524), corresponding to amino acid residues around phosphorylated Ser413. | |
| 100 μL | |
| Primary | |
| Human, Mouse, Rat | |
| Antibody | |
| IgG |
Correzione del contenuto del prodotto
Fornite il vostro feedback sul contenuto del prodotto compilando il modulo sottostante.
Titolo del prodotto
Individuate un'opportunità di miglioramento?Condividi una correzione di contenuto